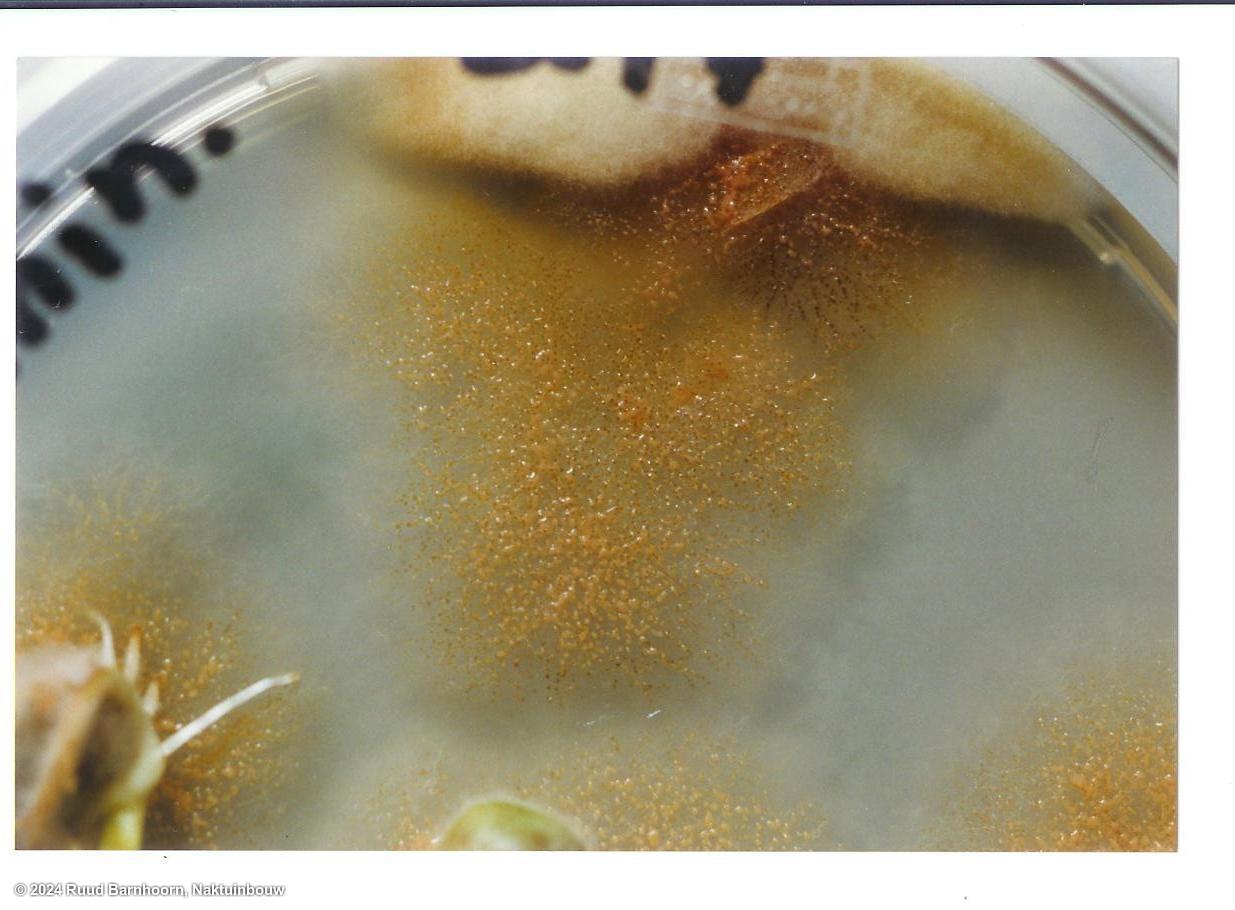

Ascochyta pisi
Overview
|
Scientific name
|
Ascochyta pisi |
|
Genus
|
Ascochyta |
|
EPPO code
|
ASCOPI |
|
Common name
|
Ascochyta blight and pod spot |
|
Synonyms
|
|
Description
After 7 days of growth in an appropriate chamber, examine seeds for abundant white mycelium with often covers infected seeds. Confirm colonies by looking for presence of wavy hyphae at the edge of the colony when examined under x25 magnification. Colony diameter typically 20-30 mm, occasionally smaller or incompletely surrounding the seed. Reverse of colonies medium to dark orange-brown centrally, opaque and even, becoming lighter in colour towards the edge of the colony. Gelatinous-looking orange-brown pycnidia often present (although only sometimes clealry visible), particularly where seed touches agar. Under STM at x20-25 magnification, using both transmitted and incident light, hyphae are curled, over several running together, typically with moisture drops (although these evaporate easily). Very limited growths from some seeds may only be seed if dishes tilted to get lighting at best angle, or under STM examination or after extended incubation. Pycnidia are up to 250 um in diamter. Spores, hyaline, cylindric, or slightly curned with rounded ends, 1-septate, slightly constricted at septum, mostly 12 x 4.5 um (Punithalingam & Holliday, 1972).